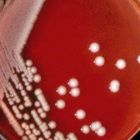
克雷伯氏菌單菌落形態
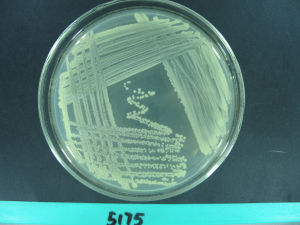
克雷伯氏菌

簡介
克雷伯氏菌單菌落形態
克雷伯氏菌單菌落形態模式種:肺炎克雷伯氏菌(Klebsiellapneumoniae)。
生理特徵
克雷伯氏菌為較短粗的桿菌,大小0.5~0.8×1~2μm,單獨、成雙或短鏈狀排列。無芽孢,無鞭毛,有較厚的莢膜,多數有菌毛。營養要求不高,有普通瓊脂培養基上形成較大的灰白色粘液菌落,以接種環挑之,易拉成絲,有助鑑別。在腸道桿菌選擇性培養基上能發酵乳糖,呈現有色菌落。生長在肉汁培養基上產生粘韌度不等的稍呈圓形有閃光的菌落,這些與菌株和培養基成分有關。不需要特殊的生長因子。氧化酶陰性。大多數菌株能利用檸檬酸鹽和葡萄糖作為唯一碳源。發酵葡萄糖產酸產氣(產生CO2多於H2),但也有不產氣的菌株。
不運動。兼性厭氧,呼吸和發酵兩種類型的代謝。
大多數菌株產生2,3-丁二醇作為葡萄糖發酵的主要末端產物,VP試驗通常陽性;與混合酸發酵比較起來形成較少的乳酸、乙酸和甲酸,而形成較多的乙醇。發酵肌醇,水解尿素,不產生鳥氨酸脫羧酶或H2S是更進一步的鑑別性狀。有些菌株固氮。見於腸道內容物、臨床樣品、土壤、水、穀物等。DNA中G+C mol%是53~58(Tm)。
具有O抗原與K抗原,後者用以分型。利用莢膜腫脹試驗,本屬K抗原可分為82型。肺炎克雷伯氏菌大多屬3型和12型;臭鼻克氏菌主要屬4型,少數為5型或6型;鼻硬結克氏菌一般屬3型,但並非所有3型均為該菌。
本屬細菌55℃30分鐘被殺死。在培養基上可存活數周至數月。
病症性
(一)肺炎克雷伯氏菌
1882年Friedlander首先從大葉性肺炎患者痰液中分離出,故也稱為Friedlander桿菌,簡稱肺炎桿菌。該菌產生胞外毒性複合物(extracellulartoxiccomplex,ETC),主要成分為莢膜多糖(63%)、脂多糖(30%)和少量蛋白質(7%)。有些菌株還可產生LT和ST腸毒素。莢膜也與致病力有關。
本菌存在於人體腸道、呼吸道。可引起支氣管炎、肺炎,泌尿系和創傷感染,甚至敗血症、腦膜炎、腹膜炎等。
(二)臭鼻克雷伯氏菌
簡稱臭鼻桿菌,引起慢性萎縮性鼻炎,有惡臭,以及敗血症、泌尿系感染等。
(三)鼻硬結克雷伯氏菌
簡稱鼻硬結桿菌,引起慢性肉芽腫性病變,侵犯鼻咽部,使組織發生壞死。
治療
克雷伯氏菌
克雷伯氏菌一般對先鋒黴素、氨基糖類(鏈黴素、慶大黴素、卡那黴素等)、氯黴素、多粘菌素等敏感。易於耐藥。
抗生素治療:不產ESBL菌落,用三代頭孢最有效,如“頭孢哌酮鈉舒巴坦鈉”(商品名:鈴蘭欣)產esbl用泰能(即亞氨培南),依據病情,注射用滴注7到14天,不可超過半個月,易發生耐藥。
克雷伯氏菌為人體本身存在菌屬,當受到感染或免疫力下降時,則發病,應注意平時鍛鍊,增強機體免疫力。
三聚氰胺毒性相關
2013年最新研究發現,腸道菌群中的克雷伯氏菌與人體三聚氰胺的代謝毒性密切相關。由於三聚氰胺被認為在人體中不吸收,難以單獨形成結石,迄今其臨床毒性機制一直不甚明了。但新研究發現,2008年中國毒奶粉中的三聚氰胺引發的嬰幼兒腎衰竭是和腸道細菌的代謝有著密切關係。一些腸道細菌,尤其是克雷伯氏菌屬的細菌,具有代謝含氮化合物的活性,能夠在腸道中代謝三聚氰胺,轉化為三聚氰酸並逐步將其降解。三聚氰胺和三聚氰酸本身毒性極低,但極易互相結合形成晶體,這兩類物質進入血液循環後,在腎小管中與尿酸結合形成大分子複合物類的結石,堵塞腎小管,導致腎毒性 。
超級細菌事件
荷蘭鹿特丹的馬斯城醫院2011年7月26日宣布,近兩個月內一種不明疫情已在荷蘭造成27人死亡,所有死亡病例均感染一種超級細菌。查詢國外相關資料得知,目前已確認這種超級細菌屬於克雷伯氏菌。此前,該病菌已經在法國等地引發疫情,只不過這次更具抗藥性。自2011年6月1日至今已經造成27人死亡。
醫院在一份聲明中說2011年7月18日以來,已經沒有進一步感染檢測首次進入醫院的病人。報告稱,78人是細菌的載體,另外1967人被診為疑似病例 。

